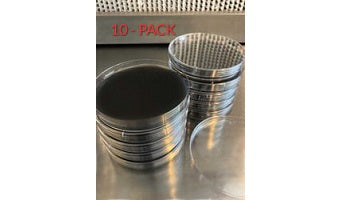

1
/
of
2
Midwest Grow Kits
Pre-Poured Sterilized BLACK MEA Agar Plates (10-Pack)
Pre-Poured Sterilized BLACK MEA Agar Plates (10-Pack)
Regular price
$ 29.99 USD
Regular price
Sale price
$ 29.99 USD
Unit price
/
per
Couldn't load pickup availability
Looking for that ultimate contrast for white mycelium and a plate that naturally defends against bacteria? Midwest's Black Agar plates are the answer. We start with the perfect blend of agar, organic malt extract, organic locust bean gum & organic yeast extract. We add pure lab grade carbon, which prevents bacterial growth while stimulating the growth of mushroom mycelium. Midwest's agar plates are made fresh daily! Most pre-poured agar plates sit for weeks before shipping. See the difference fresh makes! Each set of 10 plates are sealed in polyolefin packaging.
Features & Includes:
- 10 Sterilized Black AGAR dishes
- 100mm Polystyrene Petri Dishes
- 100% Pure lab grade carbon added
- Made with perfect blend of additives to promote healthy mycelium colonies
- Pressure sterilized & Poured in our lab using laminar flow hood
- Please store agar plates in the fridge and use within 3-4 weeks for optimal results
Share